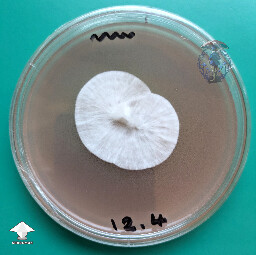
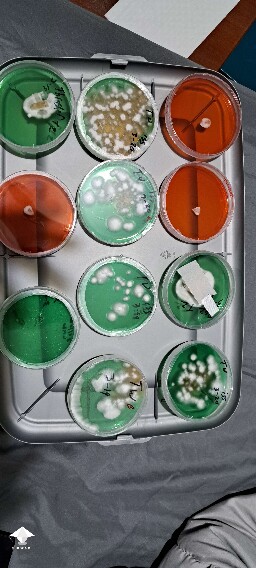
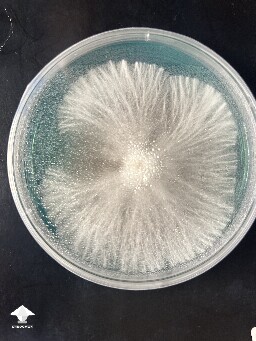
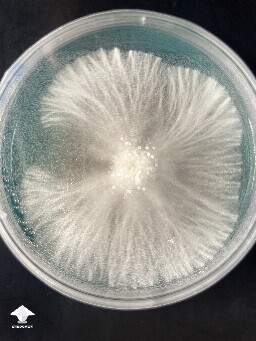
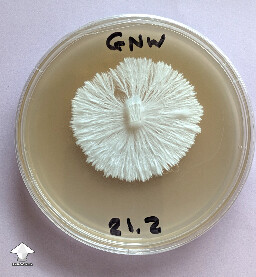
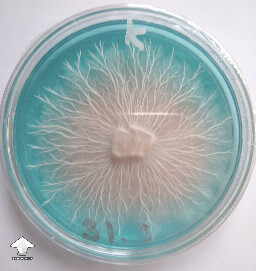
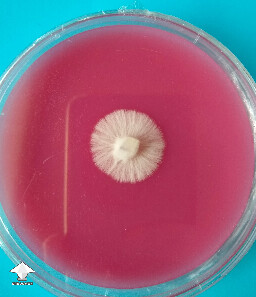

Psilocybe gallery on Shroomok
Photo gallery of mushrooms related to gene Psilocybe — gilled mushrooms that grow all over the world. It included not only the most commonly cultivated and consumed Cubensis, but more than 130 other species. Wild and cultivated. Potency charts by species
Shroomok's choice on Amazon

Load more photos